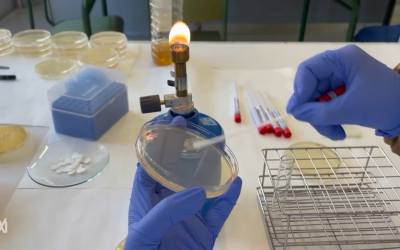
Eix microbiota i salut

Menció X(p)rimenta 2025 en la categoria Primària (Escola Josep de Ribot i Olivas, Vilamalla)...
Resultats de la cerca:
Experimenta | Física | Infantil i Primària | Tecnologia i enginyeria
Experimenta
Donem una segona vida al plàstic
juny 2, 2025
Menció X(p)rimenta 2025 en la categoria Primària (Escola Santa Caterina, Vinyols i els Arcs)...
Construïm una catapulta
juny 2, 2025
Menció X(p)rimenta 2025 en la categoria Primària (Col·legi Mare Nostrum, Tarragona) Alumnat Luna...
La densitat: experiment amb aigua i sabó
juny 2, 2025
Menció X(p)rimenta 2025 en la categoria Primària (Escola Assís, Premià de Mar) Alumnat Mael Reillo...
Quin temps fa? Xprimentem amb la densitat
juny 2, 2025
Menció X(p)rimenta 2025 en la categoria Secundària (Institut Tarragona, Tarragona) Alumnat Martina...
L’inici de l’electromagnetisme
juny 2, 2025
Menció X(p)rimenta 2025 en la categoria Secundària (Institut de l'Arboç, l’Arboç) Alumnat Debora...
La física de Newton
juny 2, 2025
Menció X(p)rimenta 2025 en la categoria Secundària (Institut Escola Els Tres Pins, Vallromanes)...
La ciència de l’Slime i els fluids no newtonians!
maig 30, 2025
Menció X(p)rimenta 2025 en la categoria Secundària (INS Montsacopa, Olot) Alumnat Eloi Sánchez...
L’efecte hivernacle
maig 30, 2025
Menció X(p)rimenta 2025 en la categoria Batxillerat i Cicles Formatius (Institut d'Argentona,...
Eix microbiota i salut
maig 30, 2025
Menció X(p)rimenta 2025 en la categoria Batxillerat i Cicles Formatius (Institut de l'Ebre,...
Quimimàgia
maig 30, 2025
Menció X(p)rimenta 2025 en la categoria Batxillerat i Cicles Formatius (INS Estela Ibèrica, Santa...
Tsunami d’aigua
maig 30, 2025
Menció X(p)rimenta 2025 en la categoria Batxillerat i Cicles Formatius (Institut la Plana, Vic)...